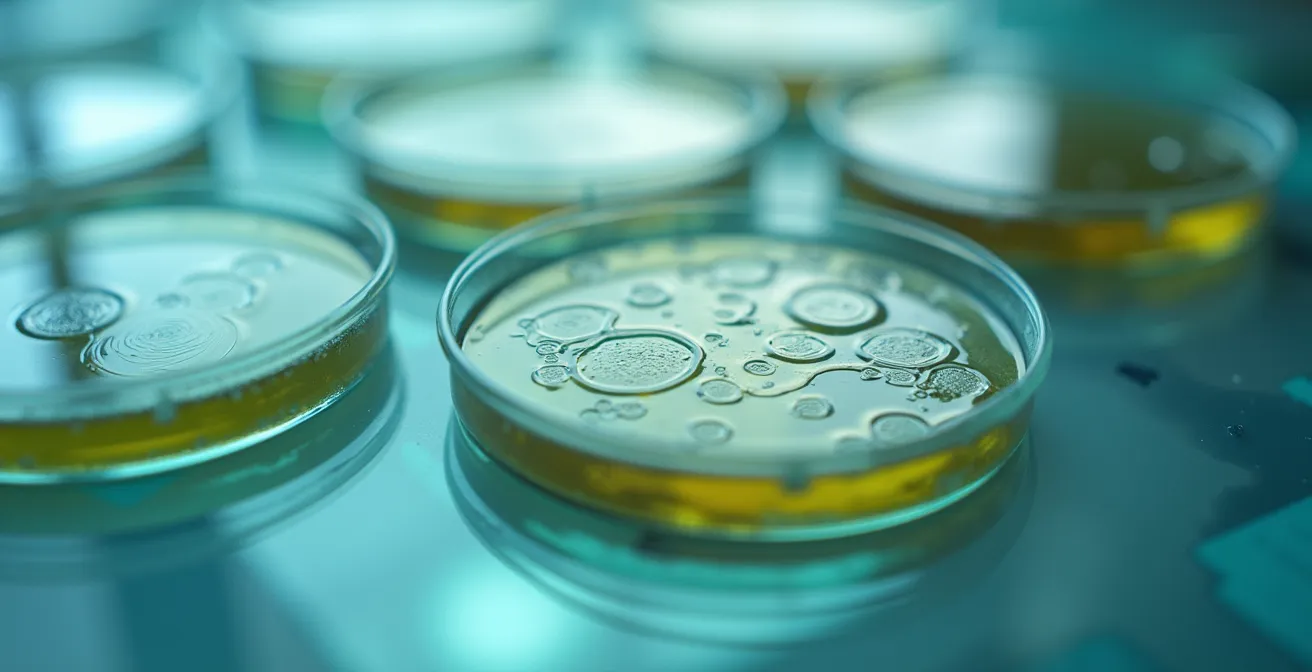
Vue microscopique de colonies bactériennes sur une boîte de Petri avec équipement de laboratoire

Choisir un désinfectant en milieu de santé n’est pas un achat, c’est la signature d’un contrat de performance et de sécurité pour protéger les patients.
- Un produit sans numéro d’identification du médicament (DIN) de Santé Canada est illégal et ses affirmations d’efficacité ne sont pas vérifiées.
- La performance d’un désinfectant hospitalier se mesure à sa capacité prouvée à agir en présence de charge organique (sang, fluides), là où les produits grand public échouent.
Recommandation : Exigez systématiquement un produit avec un DIN valide et des allégations d’efficacité (virucide, bactéricide) qui correspondent aux risques spécifiques de votre établissement.
Dans un établissement de santé, chaque surface peut devenir un vecteur de transmission. La lutte contre les infections nosocomiales est un combat de tous les instants, où le choix des outils est aussi critique que la compétence de ceux qui les utilisent. Pour un responsable des achats ou de l’hygiène, la sélection d’un produit nettoyant ou d’un désinfectant va bien au-delà d’une simple question de propreté. C’est un acte lourd de conséquences, qui engage la sécurité des patients, la santé du personnel et la réputation de l’établissement. Pourtant, face à une multitude de produits, il est facile de se fier à des arguments marketing ou à des habitudes bien ancrées.
On pense souvent que l’efficacité est le seul critère, ou que les solutions les plus « vertes » sont intrinsèquement meilleures. Mais si la véritable clé n’était pas dans les promesses de l’étiquette, mais dans la compréhension des garanties qu’elle représente ? La certification d’un produit n’est pas une simple formalité administrative. C’est un véritable contrat de performance, un engagement légal et scientifique que le fabricant prend envers vous. Savoir décoder ce contrat est la compétence la plus importante pour un gestionnaire en milieu de soins.
Cet article n’est pas un simple catalogue de produits. C’est un guide pour vous apprendre à lire entre les lignes des fiches techniques et des étiquettes. Nous allons décrypter ce que signifient réellement le numéro DIN, les normes d’efficacité contre des pathogènes comme le SARM, et comment évaluer la crédibilité des labels écologiques. En maîtrisant ces concepts, vous ne choisirez plus un produit : vous sélectionnerez une garantie de sécurité et de conformité pour votre établissement.
Pour vous guider dans cette démarche essentielle, cet article est structuré pour répondre de manière progressive et détaillée à chaque enjeu. Découvrez les points cruciaux à maîtriser pour faire des choix éclairés et sécuritaires.
Sommaire : Maîtriser le choix des désinfectants certifiés en milieu hospitalier
- Le numéro DIN sur votre désinfectant : ce qu’il signifie et pourquoi il est essentiel
- Votre produit est-il efficace contre le SARM ? Le guide pour décoder les normes d’efficacité des désinfectants
- Prêt à l’emploi ou concentré : quel format de désinfectant choisir pour votre établissement ?
- Pourquoi vous ne pouvez pas utiliser un désinfectant de supermarché dans un hôpital
- Désinfection efficace et écologique : est-ce enfin possible ?
- Bactéricide, virucide, fongicide : comment choisir le bon désinfectant pour la bonne cible
- Labels écologiques sur les produits ménagers : comment ne plus jamais se faire avoir
- L’hygiène en milieu de soins : la science de la précision au service de la sécurité des patients
Le numéro DIN sur votre désinfectant : ce qu’il signifie et pourquoi il est essentiel
Avant même d’examiner le spectre d’efficacité ou la marque d’un désinfectant, un seul élément doit capter votre attention : le numéro d’identification du médicament (DIN). Ce code à huit chiffres n’est pas un simple numéro de lot. Il s’agit de la preuve formelle que Santé Canada a examiné et validé la sécurité, l’efficacité et la qualité du produit selon des protocoles scientifiques rigoureux. En bref, un désinfectant sans DIN n’a pas le droit d’être vendu au Canada avec des allégations de désinfection. L’utilisation d’un tel produit en milieu de soins est une faute professionnelle qui expose l’établissement à des risques légaux et sanitaires inacceptables.
Ce numéro garantit que les affirmations du fabricant (par exemple, « efficace contre le virus de la grippe en 1 minute ») ont été prouvées par des tests en laboratoire standardisés. Selon la réglementation, cette exigence s’applique à 100% des désinfectants vendus légalement au Canada. Le DIN est donc votre première et plus importante ligne de défense contre les produits inefficaces ou frauduleux. Il transforme une promesse marketing en un contrat de performance vérifiable et légalement encadré.
Vérifier la validité d’un DIN est une étape simple mais cruciale de votre processus d’approvisionnement. Cela vous permet de confirmer non seulement l’existence de l’homologation, mais aussi les détails précis de celle-ci, comme les ingrédients actifs et les pathogènes cibles validés. Ne jamais tenir pour acquis qu’un produit est conforme ; la vérification est la base de toute démarche qualité en hygiène et salubrité.
Votre plan d’action pour valider un numéro DIN
- Localisez le numéro DIN à 8 chiffres sur l’étiquette du produit.
- Accédez à la Base de données sur les produits pharmaceutiques en ligne de Santé Canada.
- Entrez le numéro DIN dans le champ de recherche pour consulter la monographie officielle du produit.
- Vérifiez la correspondance des informations : ingrédients actifs, temps de contact homologué, et surtout, la liste des pathogènes ciblés.
- Confirmez que l’usage prévu et homologué (ex: surfaces dures non poreuses en milieu hospitalier) correspond précisément à vos besoins.
Votre produit est-il efficace contre le SARM ? Le guide pour décoder les normes d’efficacité des désinfectants
La présence d’un DIN est la première étape. La seconde est de s’assurer que le spectre d’efficacité du produit correspond aux menaces réelles de votre environnement. Le Staphylococcus aureus résistant à la méticilline (SARM) est l’un des défis majeurs en milieu de soins. Il ne suffit pas qu’un produit soit « bactéricide » ; il doit être spécifiquement testé et homologué pour son efficacité contre cette souche résistante. Au Québec, la menace est bien réelle : les données de l’INSPQ montrent que 8,3% des bactériémies à S. aureus sont résistantes à l’oxacilline (SARM) pour la période 2023-2024.
Pour vérifier cette efficacité, vous devez chercher sur l’étiquette ou la fiche technique du produit l’allégation spécifique « efficace contre le SARM » ou « Staphylococcus aureus résistant à la méticilline ». Cette affirmation, lorsqu’elle est associée à un DIN, signifie que le fabricant a fourni à Santé Canada des données de laboratoire prouvant que le produit détruit ce pathogène précis, dans le temps de contact indiqué. C’est ce niveau de détail qui fait la différence entre un nettoyage général et une désinfection ciblée qui protège les patients.
La surveillance constante de l’évolution des souches bactériennes, comme le fait le programme de surveillance de l’INSPQ au Québec, est essentielle. Elle permet d’adapter les protocoles et de s’assurer que les produits utilisés restent pertinents face aux menaces émergentes. Pour un gestionnaire, cela signifie qu’il faut périodiquement réévaluer son arsenal de désinfectants pour s’assurer qu’il reste aligné sur les recommandations des autorités de santé publique comme le Comité sur les infections nosocomiales du Québec (CINQ).
L’analyse en laboratoire est ce qui transforme une affirmation marketing en une garantie scientifique. Choisir un produit validé contre des pathogènes spécifiques comme le SARM, c’est s’appuyer sur cette rigueur pour construire un environnement plus sûr.
Prêt à l’emploi ou concentré : quel format de désinfectant choisir pour votre établissement ?
Une fois la conformité (DIN) et l’efficacité (spectre d’action) validées, une décision plus opérationnelle se présente : faut-il opter pour un format prêt à l’emploi (PàE) ou pour une formule concentrée à diluer ? Ce choix n’est pas anodin et a des implications directes sur la sécurité, le coût et la constance des résultats. Il n’y a pas de réponse universelle ; la meilleure solution dépend de la réalité de votre établissement, de la formation de votre personnel et de vos infrastructures.
Les produits prêts à l’emploi offrent une simplicité et une sécurité maximales. Le principal avantage est l’élimination du risque d’erreur de dilution. Une dilution incorrecte peut rendre un produit totalement inefficace (trop dilué) ou dangereux et corrosif (pas assez dilué). Le format PàE garantit que chaque application utilise la concentration exacte qui a été testée et validée par Santé Canada. C’est la solution idéale pour les zones à haut risque ou lorsque le personnel a une rotation élevée et une formation limitée sur la manipulation de produits chimiques.
Les produits concentrés, quant à eux, offrent des avantages économiques et écologiques significatifs. Ils réduisent les coûts de transport, les besoins en espace de stockage et la quantité d’emballages plastiques. Cependant, leur efficacité dépend entièrement de la rigueur du processus de dilution. Pour minimiser les risques, l’utilisation de systèmes de dilution automatisés et muraux est fortement recommandée. Ces systèmes prélèvent la juste dose de concentré et la mélangent automatiquement avec de l’eau, garantissant une solution finale parfaite à chaque fois. Investir dans de tels systèmes est une condition quasi essentielle pour adopter les concentrés de manière sécuritaire dans un hôpital.

Le choix final doit donc être le fruit d’une analyse de risques : la simplicité et la sécurité infaillible du prêt à l’emploi contre les économies potentielles du concentré, qui exigent en contrepartie un investissement en formation et en équipement de dilution.
Pourquoi vous ne pouvez pas utiliser un désinfectant de supermarché dans un hôpital
L’une des erreurs les plus graves en gestion de l’hygiène est de croire qu’un désinfectant est un désinfectant, peu importe sa provenance. Les produits disponibles en grande surface et ceux destinés au milieu hospitalier sont deux mondes à part, régis par des normes de performance radicalement différentes. La distinction fondamentale réside dans un concept technique clé : la charge organique. En milieu hospitalier, les surfaces ne sont jamais parfaitement propres avant la désinfection. Elles sont contaminées par des micro-organismes, mais aussi par du sang, des fluides corporels, des résidus de tissus, etc. C’est cela, la charge organique.
Cette charge organique a la capacité d’inactiver de nombreux agents désinfectants. Un produit qui est efficace dans une boîte de Petri en laboratoire peut devenir complètement inutile au contact de la moindre trace de sang. C’est pourquoi Santé Canada impose des tests beaucoup plus stricts pour les désinfectants hospitaliers. La réglementation exige un test d’efficacité en présence d’au moins 5% de charge organique simulant le sang pour valider les allégations de désinfection à usage hospitalier. Les produits de supermarché, eux, ne sont généralement pas testés dans ces conditions exigeantes.
Utiliser un produit domestique dans un hôpital revient à parier sur une efficacité qui n’a jamais été prouvée pour cet environnement. C’est une faille majeure dans tout protocole de prévention des infections. L’autorité de Santé Canada est très claire sur ce point, comme le rappelle son guide destiné aux fabricants.
Les désinfectants hospitaliers sont testés et homologués par Santé Canada pour leur efficacité en présence d’une charge organique, une condition qui inactive la plupart des produits domestiques.
– Santé Canada, Guide sur les exigences d’efficacité et de sécurité pour les désinfectants
En conclusion, la sélection d’un produit doit impérativement se baser sur son homologation pour un usage hospitalier. C’est la seule garantie que son contrat de performance reste valide dans les conditions réelles et difficiles d’un établissement de soins.
Désinfection efficace et écologique : est-ce enfin possible ?
La pression pour adopter des pratiques plus durables touche aussi le secteur de la santé. Cependant, la question de l’équilibre entre l’efficacité de la désinfection et l’impact environnemental est cruciale. Pendant longtemps, les produits les plus puissants étaient aussi les plus agressifs pour l’environnement et les utilisateurs. Aujourd’hui, grâce aux avancées en chimie verte, il est de plus en plus possible de concilier ces deux impératifs, à condition de savoir se fier aux bonnes certifications.
Le terme « écologique » ou « vert » n’étant pas réglementé, il peut être utilisé abusivement à des fins marketing (greenwashing). Pour un gestionnaire en santé, la seule approche valable est de se fier à des certifications tierces, crédibles et reconnues, qui évaluent à la fois l’impact environnemental et la performance du produit. Au Canada, le label ÉcoLogo est la référence en la matière. Cette certification garantit non seulement que le produit respecte des critères environnementaux stricts (biodégradabilité, faible teneur en composés organiques volatils, etc.), mais aussi qu’il répond aux exigences d’efficacité pour son usage prévu.
Un produit certifié ÉcoLogo et possédant un DIN est donc la preuve que la performance n’a pas été sacrifiée sur l’autel de l’écologie. C’est un double contrat de performance : l’un pour l’efficacité biocide, validé par Santé Canada, l’autre pour la réduction de l’impact environnemental, validé par UL (Underwriters Laboratories).
Étude de cas : La double garantie de la certification ÉcoLogo
La certification ÉcoLogo, initialement créée par le gouvernement canadien, est aujourd’hui gérée par l’organisation mondiale de sécurité scientifique UL. Elle est la certification environnementale la plus reconnue au Canada pour les produits de nettoyage. Son processus d’évaluation est complet : il analyse le cycle de vie du produit, de sa formulation à son emballage. Fait crucial pour le secteur de la santé, les produits certifiés ÉcoLogo doivent également démontrer leur efficacité selon les normes en vigueur. Ainsi, un désinfectant ÉcoLogo a prouvé qu’il était à la fois moins nocif pour l’environnement et tout aussi capable de détruire les pathogènes visés qu’un produit conventionnel.

La quête d’une désinfection plus verte en milieu hospitalier est donc possible, mais elle doit être guidée par la science et la certification, et non par des allégations marketing vagues.
Bactéricide, virucide, fongicide : comment choisir le bon désinfectant pour la bonne cible
Choisir un désinfectant ne se limite pas à vérifier son DIN ; il faut affiner la sélection en fonction de la menace spécifique que vous cherchez à neutraliser. Les termes bactéricide, virucide, fongicide et sporicide ne sont pas des synonymes. Chacun désigne une capacité distincte à détruire un type de micro-organisme. Un protocole de désinfection efficace repose sur l’utilisation du bon « outil » pour le bon « travail ». Utiliser un simple bactéricide lors d’une éclosion de norovirus (un virus) est aussi inefficace que de ne rien faire.
Voici ce que ces termes signifient dans le cadre de votre contrat de performance :
- Bactéricide : Le produit est efficace contre les bactéries. C’est le niveau de base pour un désinfectant, mais il faut vérifier contre quelles bactéries spécifiques (ex: SARM, VRE).
- Virucide : Le produit inactive les virus. Il est crucial de distinguer les virus enveloppés (plus faciles à tuer, comme la grippe ou les coronavirus) des virus non-enveloppés (très résistants, comme le norovirus ou le rotavirus). L’allégation doit être précise.
- Fongicide : Le produit détruit les champignons et levures (ex: Candida albicans, Aspergillus). Important pour les environnements humides ou les patients immunodéprimés.
- Sporicide : C’est le plus haut niveau d’efficacité. Le produit est capable de détruire les spores bactériennes, des formes de vie extrêmement résistantes comme celles du Clostridioides difficile (C. difficile), une cause majeure d’infections nosocomiales graves. Seuls les produits portant explicitement l’allégation « sporicide » doivent être utilisés pour les cas de C. difficile.
Le temps de contact est l’autre variable cruciale de l’équation. C’est la durée pendant laquelle la surface doit rester visiblement humide pour que le produit ait le temps de détruire le pathogène. Un produit avec un temps de contact de 10 minutes est souvent irréaliste en pratique, car la surface sèche avant. Privilégiez des produits avec des temps de contact courts et validés (1 à 3 minutes) pour assurer une application conforme et efficace par le personnel d’entretien.
La sélection doit donc être guidée par une analyse de risque. En prévention générale, un produit bactéricide et virucide à large spectre peut suffire. En cas d’éclosion ou de cas identifié, il est impératif d’ajuster le protocole et d’utiliser un produit dont le spectre d’action couvre spécifiquement le pathogène en cause. La fiche technique du produit est votre document de référence pour valider ces capacités.
Labels écologiques sur les produits ménagers : comment ne plus jamais se faire avoir
L’attrait pour les produits « verts » est légitime, mais le manque de réglementation autour de termes comme « naturel » ou « écologique » a créé une jungle de logos et d’allégations souvent trompeuses. Pour un acheteur professionnel, naviguer dans cet univers sans se faire avoir exige une approche structurée. Il ne faut pas mettre tous les labels dans le même panier ; leur crédibilité varie énormément. On peut les organiser selon une pyramide de crédibilité pour prendre des décisions éclairées.
Au sommet de la pyramide se trouvent les certifications par une tierce partie indépendante, basées sur des normes publiques et transparentes. C’est le cas d’ÉcoLogo (UL) au Canada ou de Green Seal aux États-Unis. Ces labels garantissent qu’un produit a été audité par un organisme indépendant sur une multitude de critères (cycle de vie, toxicité, performance). C’est le plus haut niveau de confiance que vous puissiez avoir.
Juste en dessous, on trouve les certifications gouvernementales ou réglementées, comme Energy Star pour l’efficacité énergétique. Ces labels sont fiables car ils reposent sur des standards définis par la loi et une surveillance étatique. Viennent ensuite les certifications d’associations sectorielles (ex: FSC pour le bois), qui sont généralement crédibles mais peuvent parfois manquer d’indépendance totale. Enfin, tout en bas de la pyramide, se trouvent les auto-déclarations marketing. Des termes vagues comme « doux pour la planète », « formule verte » ou « inspiré de la nature », sans le sceau d’une certification tierce, n’ont aucune valeur vérifiable et relèvent souvent du greenwashing. En milieu de santé, ces allégations ne devraient jamais être un critère de sélection.
Le tableau suivant, inspiré des guides de l’Office de la protection du consommateur du Canada, résume cette hiérarchie pour vous aider à évaluer rapidement la fiabilité d’un label écologique. Comme le montre cette analyse comparative des labels environnementaux, la présence d’un audit indépendant est le principal marqueur de crédibilité.
| Niveau de Crédibilité | Type de Certification | Exemples | Caractéristiques |
|---|---|---|---|
| TRÈS ÉLEVÉ | Certifications tierces avec normes publiques | ÉcoLogo (UL), Green Seal | Audit indépendant, critères transparents, reconnaissance internationale |
| ÉLEVÉ | Certifications gouvernementales | Energy Star, Canada Organic | Normes réglementées, surveillance gouvernementale |
| MOYEN | Certifications d’associations | FSC, MSC | Standards sectoriels, audit externe |
| FAIBLE | Auto-déclarations marketing | ‘Naturel’, ‘Vert’, ‘Écologique’ | Aucune vérification externe, termes non réglementés |
À retenir
- Le DIN n’est pas négociable : C’est la preuve légale de l’homologation par Santé Canada. Pas de DIN, pas d’achat.
- La performance se mesure en contexte : Un désinfectant hospitalier doit être efficace en présence de charge organique, contrairement à un produit domestique.
- Le spectre d’action doit être ciblé : Assurez-vous que le produit est validé contre les pathogènes pertinents pour votre établissement (SARM, C. difficile, norovirus).
L’hygiène en milieu de soins : la science de la précision au service de la sécurité des patients
En définitive, la gestion de l’hygiène en milieu de soins ne peut être une affaire d’approximation. Elle doit être abordée comme une discipline scientifique, où chaque décision est basée sur des données, des preuves et des protocoles rigoureux. Les infections nosocomiales ne sont pas une fatalité ; elles sont une menace quantifiable qui exige une réponse structurée. Selon les estimations citées par le Ministère de la Santé et des Services sociaux du Québec, on estime que 5 à 15% des patients hospitalisés développent une infection nosocomiale. Ce chiffre souligne l’ampleur de l’enjeu et la responsabilité qui incombe aux gestionnaires.
L’approche scientifique se matérialise par la surveillance épidémiologique, comme celle menée par le programme SPIN de l’INSPQ. En suivant l’évolution des infections, on peut adapter les stratégies de prévention en temps réel. Cette même rigueur doit s’appliquer au choix des produits. Chaque produit sélectionné doit être vu comme un outil de précision, choisi pour sa capacité démontrée à neutraliser une menace identifiée dans des conditions spécifiques. Le contrat de performance que représentent le DIN et les allégations validées est le fondement de cette approche.
Cela signifie de résister à la tentation de choisir un produit sur la base du prix seul, ou sur des allégations marketing non vérifiées. Un produit moins cher mais inefficace ou non conforme coûtera infiniment plus cher à l’établissement en termes de risques sanitaires, de réputation et de responsabilité légale. La véritable économie réside dans le choix de la conformité et de l’efficacité prouvée. En adoptant cette philosophie, un responsable des achats passe du statut de simple acheteur à celui d’acteur clé dans la chaîne de sécurité des patients.
Pour mettre en application ces principes, l’étape suivante consiste à auditer votre inventaire actuel de produits de nettoyage et de désinfection. Évaluez chaque produit à l’aune des critères de conformité et d’efficacité décrits dans ce guide pour garantir la sécurité de votre établissement.
Questions fréquentes sur le choix des désinfectants en milieu de soins
Un temps de contact de 10 minutes est-il vraiment nécessaire?
Non, c’est souvent irréaliste en pratique car la surface sèche avant. Un tel temps de contact est souvent le signe d’un produit moins performant. Privilégiez les produits avec des temps de contact de 1 à 3 minutes, qui sont plus faciles à respecter par le personnel et dont l’efficacité a été validée par Santé Canada dans ce court laps de temps.
Quelle est la différence entre bactéricide et virucide?
Un produit bactéricide est conçu pour détruire les bactéries, tandis qu’un produit virucide inactive les virus. Ces deux capacités sont distinctes et doivent être prouvées séparément. Un désinfectant à large spectre de qualité hospitalière doit généralement posséder les deux propriétés, et l’étiquette doit spécifier contre quels types de virus il est efficace (enveloppés ou non-enveloppés).
Comment savoir si un produit est efficace contre les spores?
La capacité à détruire les spores (comme celles de C. difficile) est la plus difficile à atteindre. Un produit ne peut être considéré comme efficace que s’il porte l’allégation explicite « sporicide » sur son étiquette, une allégation qui doit être homologuée via un DIN par Santé Canada. Un simple « bactéricide » ou « désinfectant » n’est pas suffisant pour éliminer les spores.